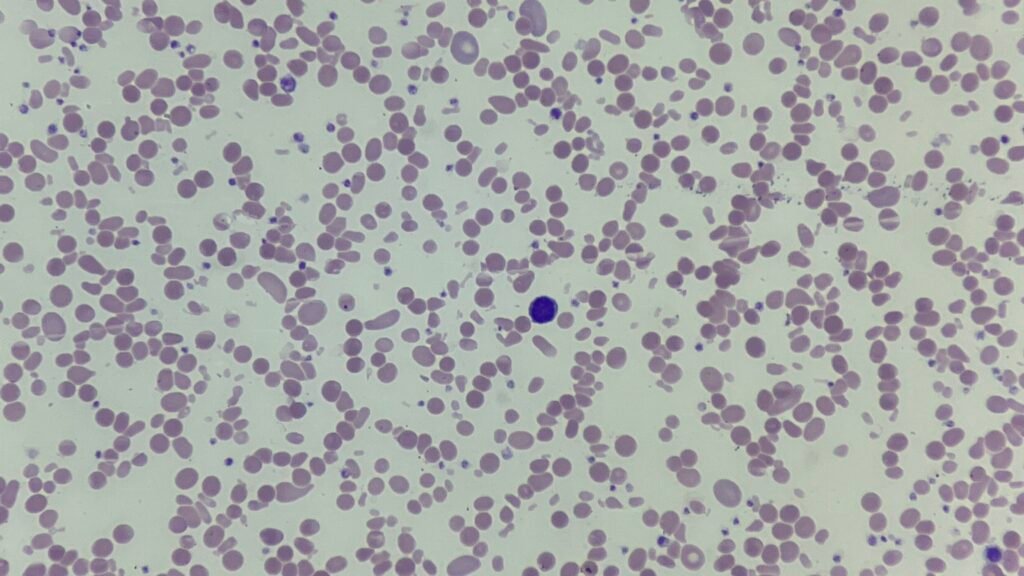
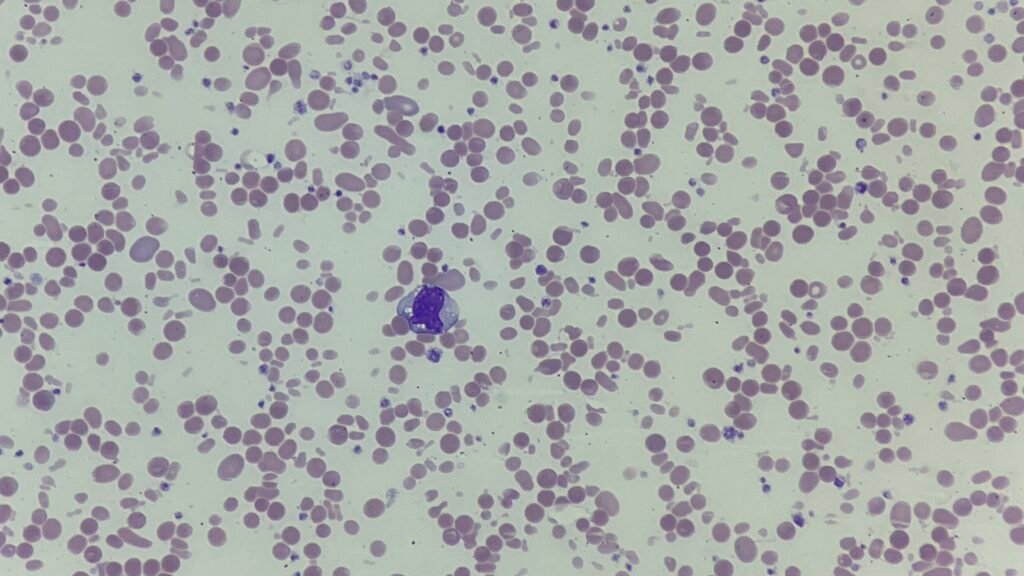
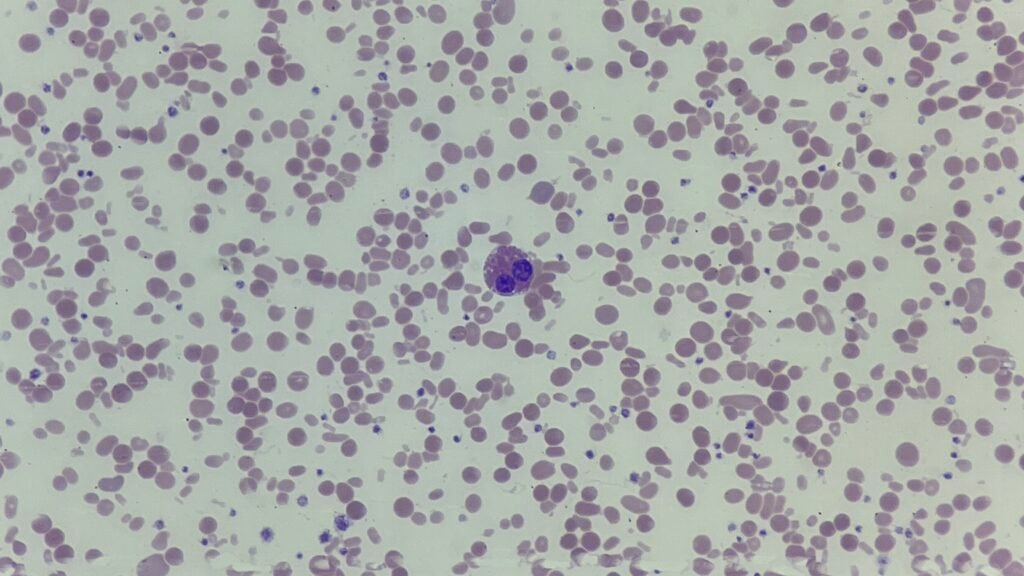
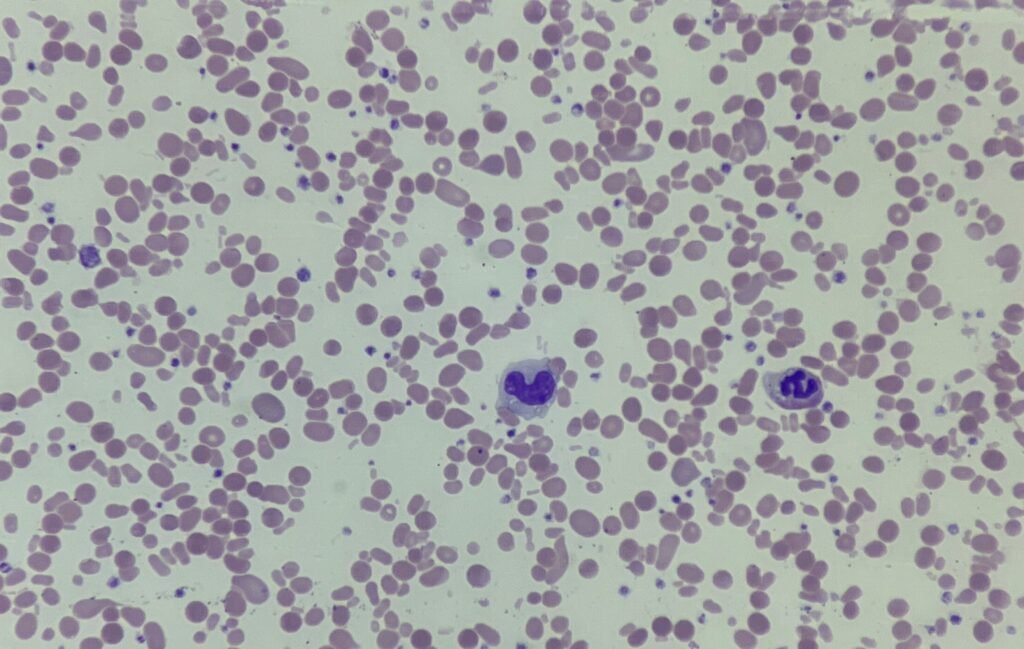
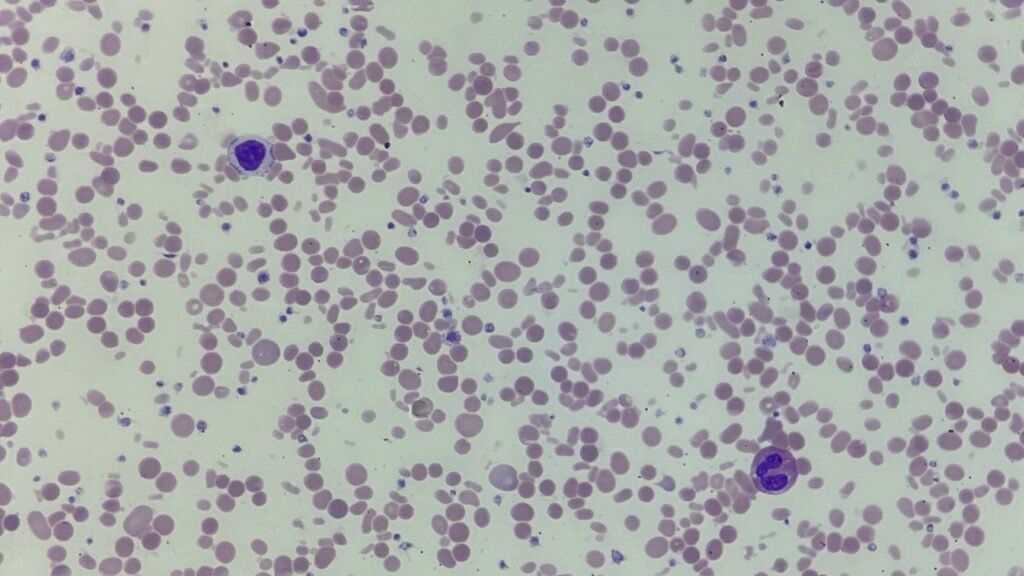

This week’s case featured a 6-year-old with chronic anaemia, intermittent jaundice, and splenomegaly. The laboratory results showed:
- Hb: 78 g/L
- MCV: markedly reduced at 55 fL
- MCHC: 360 g/L
- Reticulocytes: 9%
- Indirect bilirubin: raised
- LDH: elevated
- DAT: negative

The blood film demonstrated striking red cell fragmentation with marked anisopoikilocytosis, microspherocytes, and budding cells, giving an appearance reminiscent of thermal burns – a hallmark of Hereditary Pyropoikilocytosis (HPP).
Why HPP?
HPP is a rare inherited red cell membrane disorder, usually considered a severe variant of hereditary elliptocytosis. The condition is characterised by:
- Very low MCV despite significant anaemia
- Marked poikilocytosis with bizarre-shaped cells on the film
- DAT-negative haemolysis
- Family history (often positive, though not always available)
The clinical features of recurrent anaemia, jaundice, and splenomegaly, together with the distinctive film and laboratory findings, point towards Hereditary Pyropoikilocytosis as the diagnosis.